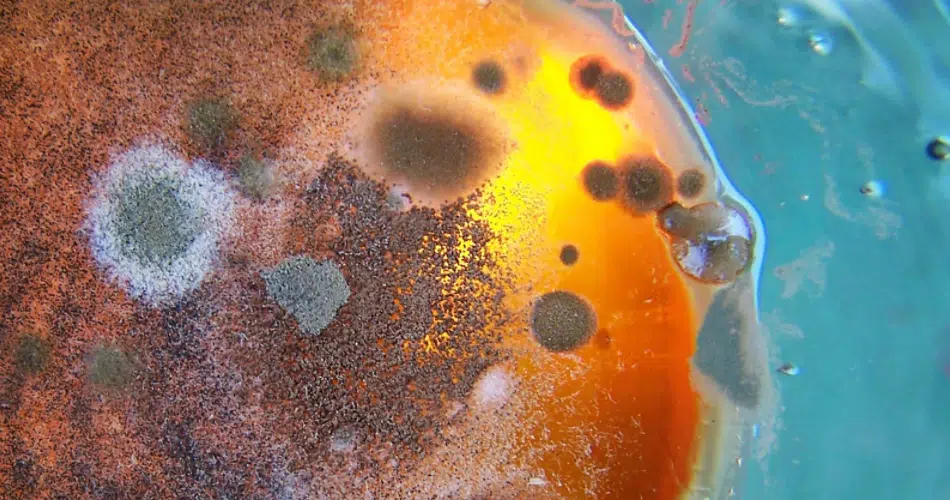

"Les spiritueux sans alcool sont une bonne chose"... C'est le constat que l'on faisait il y a quelques années quand ceux-ci étaient encore aux balbutiements. Outre la problématique du nom, car c'est un peu un non sens d'appeler ça un spiritueux sans alcool... mais pour des raisons de lisibilité de l'article, nous utiliserons ce nom pour regrouper les différentes boissons sans alcool de type bières, vins, ou spiritueux sans alcool.
Une bonne chose car il y a désormais la possibilité d'avoir des produits de qualité pour ceux et celles qui ne veulent ou ne peuvent boivent pas boire d'alcool. Ou juste par envie de ne pas avoir la tête à l'envers lors des déjeuners. D'ailleurs, l'engouement est au rendez-vous : de grands groupes de spiritueux ont lancé leurs produits, et de plus petites se sont lancées sur ce créneau alléchant. Sans parler des marques de bières dont les rayons bières débordent de références 0.0 (traduire sans alcool). Un corps sain sans un esprit sain ? Pas si sûr...
Les produits sans alcool : la course au bien être...
Le sans alcool (que ce soit bière, apéritif ou spiritueux) jouent tous ou presque la carte de la santé et du bien-être. Avec une promesse : fini la gueule de bois ! Et cela à grand renfort de pub ! Car le grand avantage des produits sans alcool est qu'il permet aux groupes de communiquer plus facilement en France vis-à-vis de la Loi Évin. Imaginez Heineken qui distribue des bières sur des aires d'autoroute ? Eh bien oui, avec Heineken 0.0 c'est possible. C'est malin et ils seraient en effet bien bête de ne pas en profiter. Certains addictologues (voir le reportage Capital sur M6 dédié au phénomène) y voient même un moyen d'aller draguer un public plus jeune... Un poil tiré par les cheveux ? On vous laisse vous faire votre avis...

Mais une catastrophe d'un point de vue nutritionnel et écologique ...
Pour créer un "alcool sans alcool," il existe plusieurs techniques, dont l'évaporation sous vide ou encore la colonne à cônes rotatifs. Des machines qui nécessitent de l'espace, mais également des montants à l'achat non négligeables. Résultat : certains (beaucoup) préfèrent sous-traiter cela à des entreprises spécialisées dans la desalcoolisation, situées dans d'autres pays à plusieurs milliers de kilomètres. Résultat : votre vin, bière, spiritueux sans alcool se tape un aller-retour en camion-citerne de plusieurs milliers de kilomètres juste pour ça. Ensuite, ce sont des techniques qui demandent encore de l'énergie (moins pour l'évaporation sous vide) et qui ont des rendements pas terribles puisque la technique de colonne à cône rotatif peut atteindre 30% de perte… Déjà que l'industrie des spiritueux est loin d'être la plus vertueuse, mais cette fois-ci pour le bilan carbone, on repassera...
Et est-ce que ce que vous buvez est sain pour votre santé ? Car c'est un peu l'argument que l'on nous vend à toutes les sauces : "L'alcool c'est le mal, le sans alcool c'est le bien". Sauf qu'enlever l'alcool pose un vrai problème : la conservation des produits. Et là, c'est le moment de commencer à regarder les étiquettes, car les produits sans alcool tombent dans le domaine de l'agroalimentaire. Entre la bière sans alcool qui utilise à balle de sirop de glucose (bonjour diabète, obésité, hypertension...), ou un autre qui utilise 7 additifs dont plusieurs considérés comme potentiellement dangereux (Benzoate de sodium par exemple...), on peut se poser des questions sur les effets sur la santé .

Des problèmes de goût et de conservation...
Alors, pourquoi utiliser des saloperies pareilles dans ces produits ? Car en enlevant l'alcool de ses produits, on supprime également une partie de leurs arômes. D'où l'intérêt de compenser avec des ajouts dans la plupart des cas. Mais surtout, on supprime l'effet conservateur naturellement présent. Et si boire une bière sans alcool en quelques minutes ne pose pas de problèmes pour la conservation, garder une bouteille de spiritueux sans alcool plus d'un mois ouverte pose de réelles problématiques pour éviter la venue de champignons et autres saloperies guère appétissantes ni plaisantes pour votre système immunitaire...
Donc on fait quoi ?
Il ne faut pas jeter le bébé avec l'eau du bain. Certains font les choses mieux que d'autres et on continue de penser que les spiritueux sans alcool sont une bonne chose... Mais pensez à bien lire les étiquettes pour voir ce que contient vraiment ce que vous vous apprêtez à boire.


Salut,
Je viens de lire ton article et tu as entièrement raison 🙂
il faut lire les etiquettes et les comprendre car dire qu´un spiritueux est sans alcool c´est bien, faut il encore qu´il soit réellement SANS ALCOOL!
Cheers Sylvie.
Oops, j´ai oubie de te dire qu´il y a une autre façon de presenter un spiritueux sans alcool Arkay est une eau aromatisée au goût de vodka avec la sensation le peps d un alcool dans la bouche .. et Arkay n est pas une boisson distillée 🙂
[…] le cas échéant). Mais sinon, histoire d’en rajouter une couche, j’ai bien aimé cette petite tribune chez For Georges […]